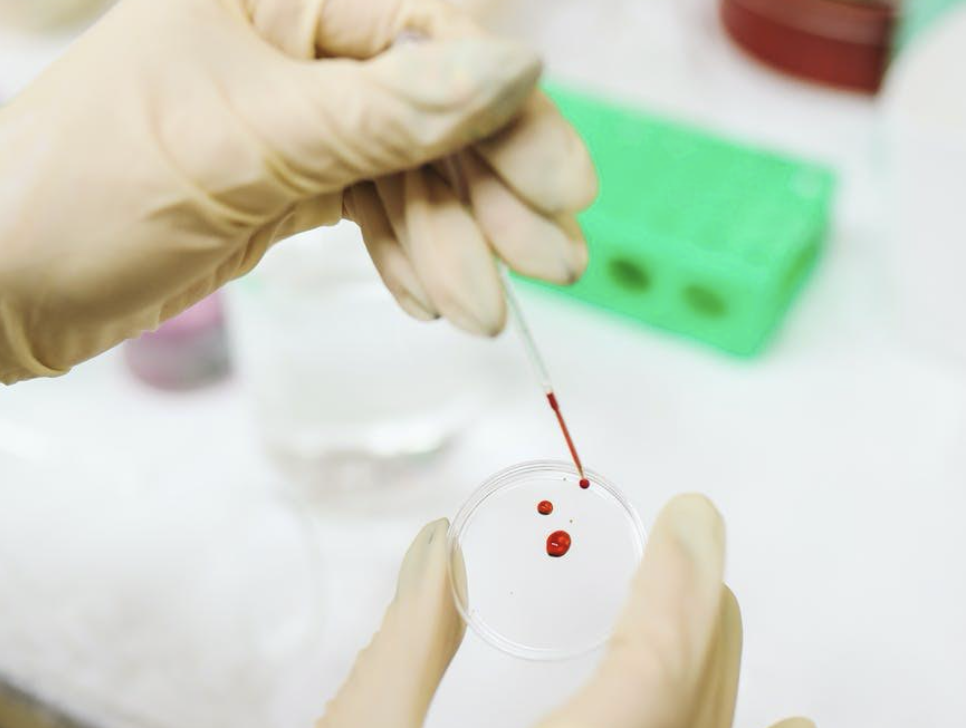
研發新藥平均時間為10-12年，且需投入大量資金與心力。（Pexels）

有國家隊領軍籌資,台灣新藥廠有了資金的注入,使得研發更順利。本刊調查,一般新藥的研發及通過三期的臨床實驗時間,平均為10至12年左右,接下來還得申請藥證,等藥證過關後,才能在該國使用。
在全世界稱羨的台灣健保制度下,國民健康保險署幫助了無數患者,健保署依單次送審案件計算,自申請文件齊全受理至藥價生效為止,平均數為9.7個月。同時健保署指出,為讓藥價制定的機制公正公開透明,已經將給付流程將與食藥署查驗登記流程相接軌,還組成全球首發新藥核價諮詢小組。藥華藥的新一代長效型干擾素,與懷特生技所研發針對癌因性疲憊症用新藥都是在去年申請,預計可在今年通過健保給付。

今年度,健保署也編列了35億在新醫療科技費用療法及新藥,而健保署對於新藥的價格核定,會以「全民健康保險藥物給付項目及支付標準」為依據,原則上都以十國藥價中位數為核價基礎。「如此制定,除了讓本土新藥在台灣價格與國際接軌,不會被盲目壓低、更有競爭力,也讓國外新藥在台販售價格與國際一致,增加國外新藥來台的機會。」生技業者私下透露。
健康保險署則表示,「為鼓勵藥廠能針對我國特有疾病投入研究,讓國人可儘早使用到適當的新藥治療,對於在我國為國際間第一個上市,又具有增進療效、減少不良反應或降低抗藥性等臨床價值之新藥,健保訂定鼓勵之核價措施,可以參考藥品市場交易價格、成本計算法、治療類似品或核價參考品之十國藥價等方式訂價。」